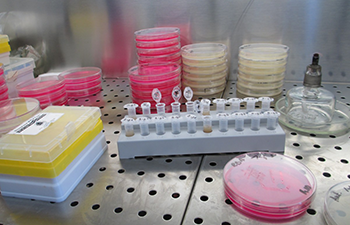
Protein Production, Strasbourg, France

View All Protein & RNA Production at Instruct
Sample preparation is not only a key issue for structural and molecular biology studies, but concerns life sciences development as a whole. Instruct centre France 1 offers state-of-the-art infrastructures for the expression and production of biomolecules and their complexes. The center proposes recombinant expression of protein and multi-protein complexes in prokaryotic and eukaryotic hosts as well as biomass production for isolation of poorly abundant proteins and endogenous complexes.
IGBMC Strasbourg bacterial expression platform combines (i) a large set of expression vectors for Escherichia coli and (ii) parallelized protocols, which enable a broad screening of soluble protein expression through the use of multiple fusion proteins and various growth conditions. IGBMC Strasbourg bacterial platform has also a long standing and unique expertise in protein complexes reconstitution and production by multi-expression in Escherichia coli. This technology is fully compatible with the parallelized protocols used for single expression. The facility is equipped with standard temperature controlled shakers as well as with two fermenters (30 and 100 L) for bacterial and yeast cultivation that can be used when large scale recombinant expression is needed or for biomass production in view of purification of protein/complexes expressed at the physiological level.
The insect cells expression platform is dedicated to protein and multi-protein complex production in insect cells using the baculovirus expression system for structural biology as well as for functional studies. It includes streamlined procedures for (i) the generation of recombinant baculovirus (transfections, co-transfections) and amplification of a high titer viral stock, (ii) evaluation of recombinant baculovirus and expression optimization using adherent cells or suspensions and (iii) protein expression in various scales and formats including production of multi-protein complexes. The IGBMC facility is equipped with a dedicated environment for baculovirus production with a 27°C temperature controlled room and a set of shakers allowing both expression screening and large scale productions at the 1-6 litre scale.
IGBMC-CERBM Strasbourg provides expression in mammalian cells based transient transfection or using the Vaccinia Virus system. For the latter, over expression of proteins can also be achieved in hamster BHK21 cells using an attenuated vaccinia virus vector (Modified Vaccinia Virus Ankara-MVA that is user safe and may be handled under BSL1 conditions). Genes of interest are cloned downstream of a bacteriophage T7 promoter within a specialized plasmid for transfer into the viral genome by homologous in vivo recombination. Virus recombinants are isolated within a few weeks in a series of selection steps using fluorescent markers. Viral recombinants are then used to produce protein in suspension cultures of hamster cells. The IGBMC facility is equipped to produce 10-20 litre batches of mammalian cells, allowing both large scale recombinant expression and biomass production for isolation of endogenous protein/complexes (expressed in physiological conditions under the control of their natural promoters).
For purification and subsequent research purposes, the protein has to be brought into solution by breaking the tissue or cells containing it. Several methods of cell lysis are commonly used to achieve this: mechanical disruption, sonication using high frequency sound waves, liquid homogenization and freeze/thaw cycles. The choice of the lysis method depends on the type of cells (bacteria, yeast, mammalian cells, etc), the volume of cell suspension and the fragility of the proteins to be recovered. The composition of the lysis buffer is also crucial to maintain the proteins of interest in the soluble fraction after cell breakage.
Access to the platform allows users to perform small-scale tests to evaluate expression strategies and construct(s), and to produce samples at a larger scale for biochemical and structural investigations.
We offer different modes of access:
Support includes training and supervision, as well as help with data analysis which is especially crucial for complex reconstitution. Users should not hesitate to contact us before submitting an application.
IGBMC/CBI-Biostructure-Strasbourg